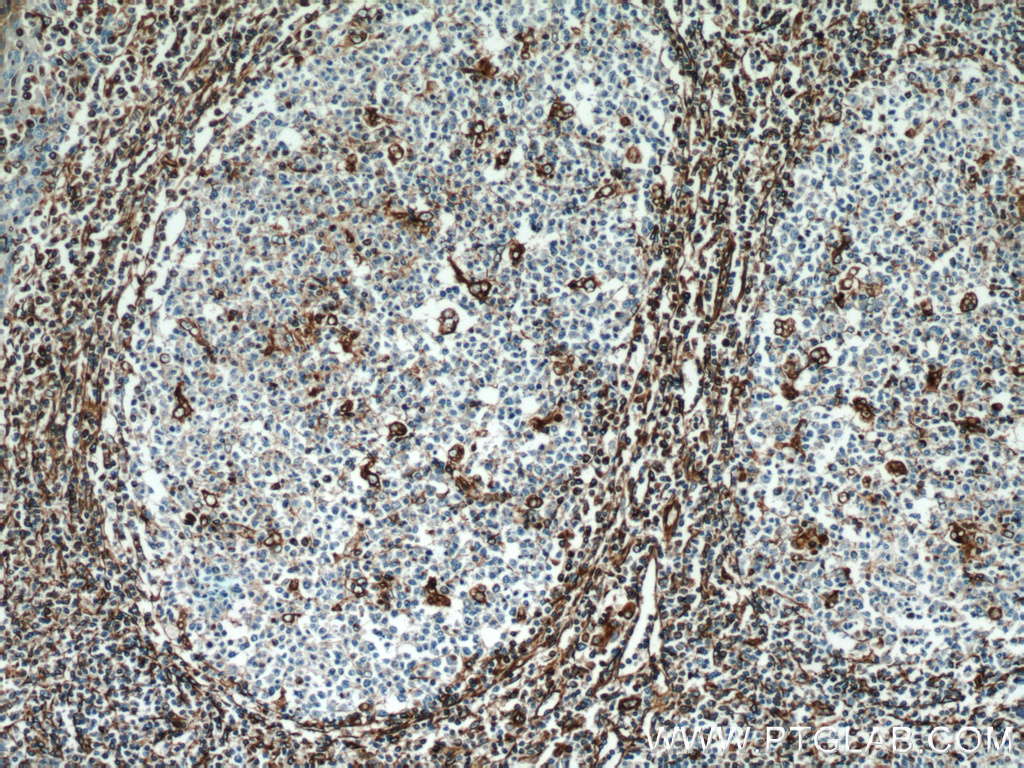
10366-1-ap;human tonsillitis tissue

tonsillitis

how i treated my chronic tonsillitis
图片尺寸496x496
y凡响 一清片 48片 清热泻火解毒牙龈肿痛扁桃体炎咽炎牙龈炎
图片尺寸800x800
预订tonsillitis: everything you need to know about t
图片尺寸307x400
1度,没有特别在意,睡完午觉39.4度.
图片尺寸1708x1280
tonsillitis and adenoids - ahmad:扁桃体和腺样体-艾哈迈德_第3页
图片尺寸1500x1125
不用打点滴,不用天
图片尺寸960x1280
科学育儿# #动态贡献者奖励计划# 慢性扁桃体炎需不需要手术治疗?
图片尺寸1815x1280
扁桃体炎可致肾病加重,要不要摘除以除后患 哪些肾
图片尺寸2251x1280
how to cope with tonsillitis (from experience)
图片尺寸700x875
10366-1-ap;human tonsillitis tissue
图片尺寸1024x768
65g*24片 清热解毒急慢性扁桃体炎所致咽喉肿痛
图片尺寸800x800
扁桃体炎可致肾病加重,要不要摘除以除后患 哪些肾
图片尺寸2560x1280
就医搜不容忽视的致命咽喉痛急性会厌炎2小时内可致命
图片尺寸650x488
金桃 板蓝根颗粒 10g*20袋 咽喉肿痛 急性扁桃体炎
图片尺寸800x800
这其中的道理很简单,脾主运化,身体吃进去的食
图片尺寸1218x1280
25g*36粒扁桃体炎急慢性咽炎清热
图片尺寸800x800
孩子反复扁桃体炎发作,日常养护5点要注意: 1,注意
图片尺寸1493x1280
地奥 银黄含片 24片/盒 清热 解毒 消炎 急性扁桃体炎 急性咽炎
图片尺寸800x800
日本进口咽喉喷雾剂咽炎喉咙痛干痒干咳咽喉痛肿扁桃体炎喷雾剂
图片尺寸800x800
扁桃体炎嗓子化脓嗓疼咽喉炎绝技神药搭配 忽然就发烧
图片尺寸960x1280